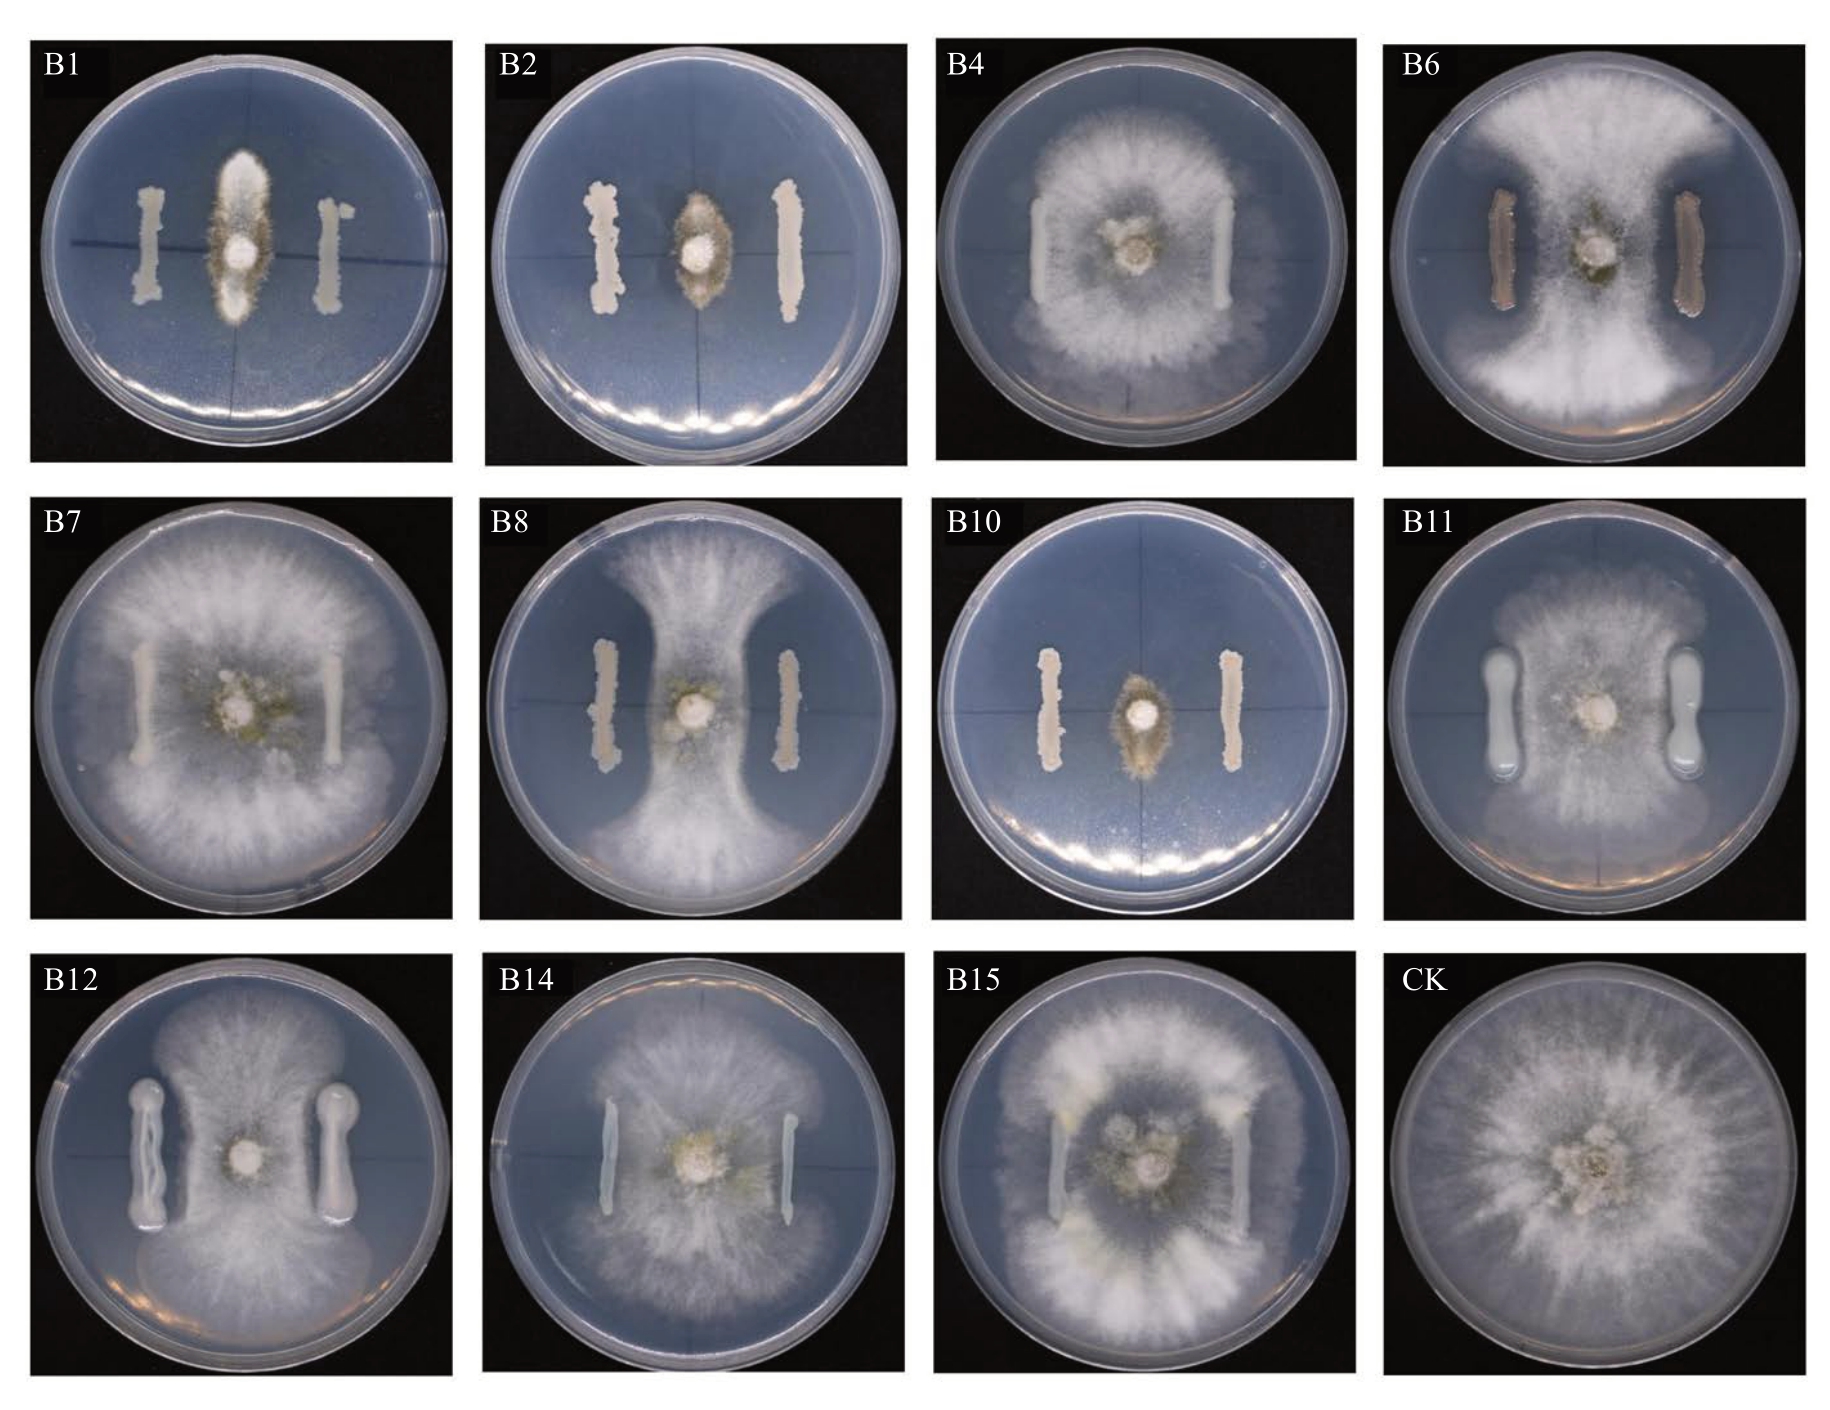
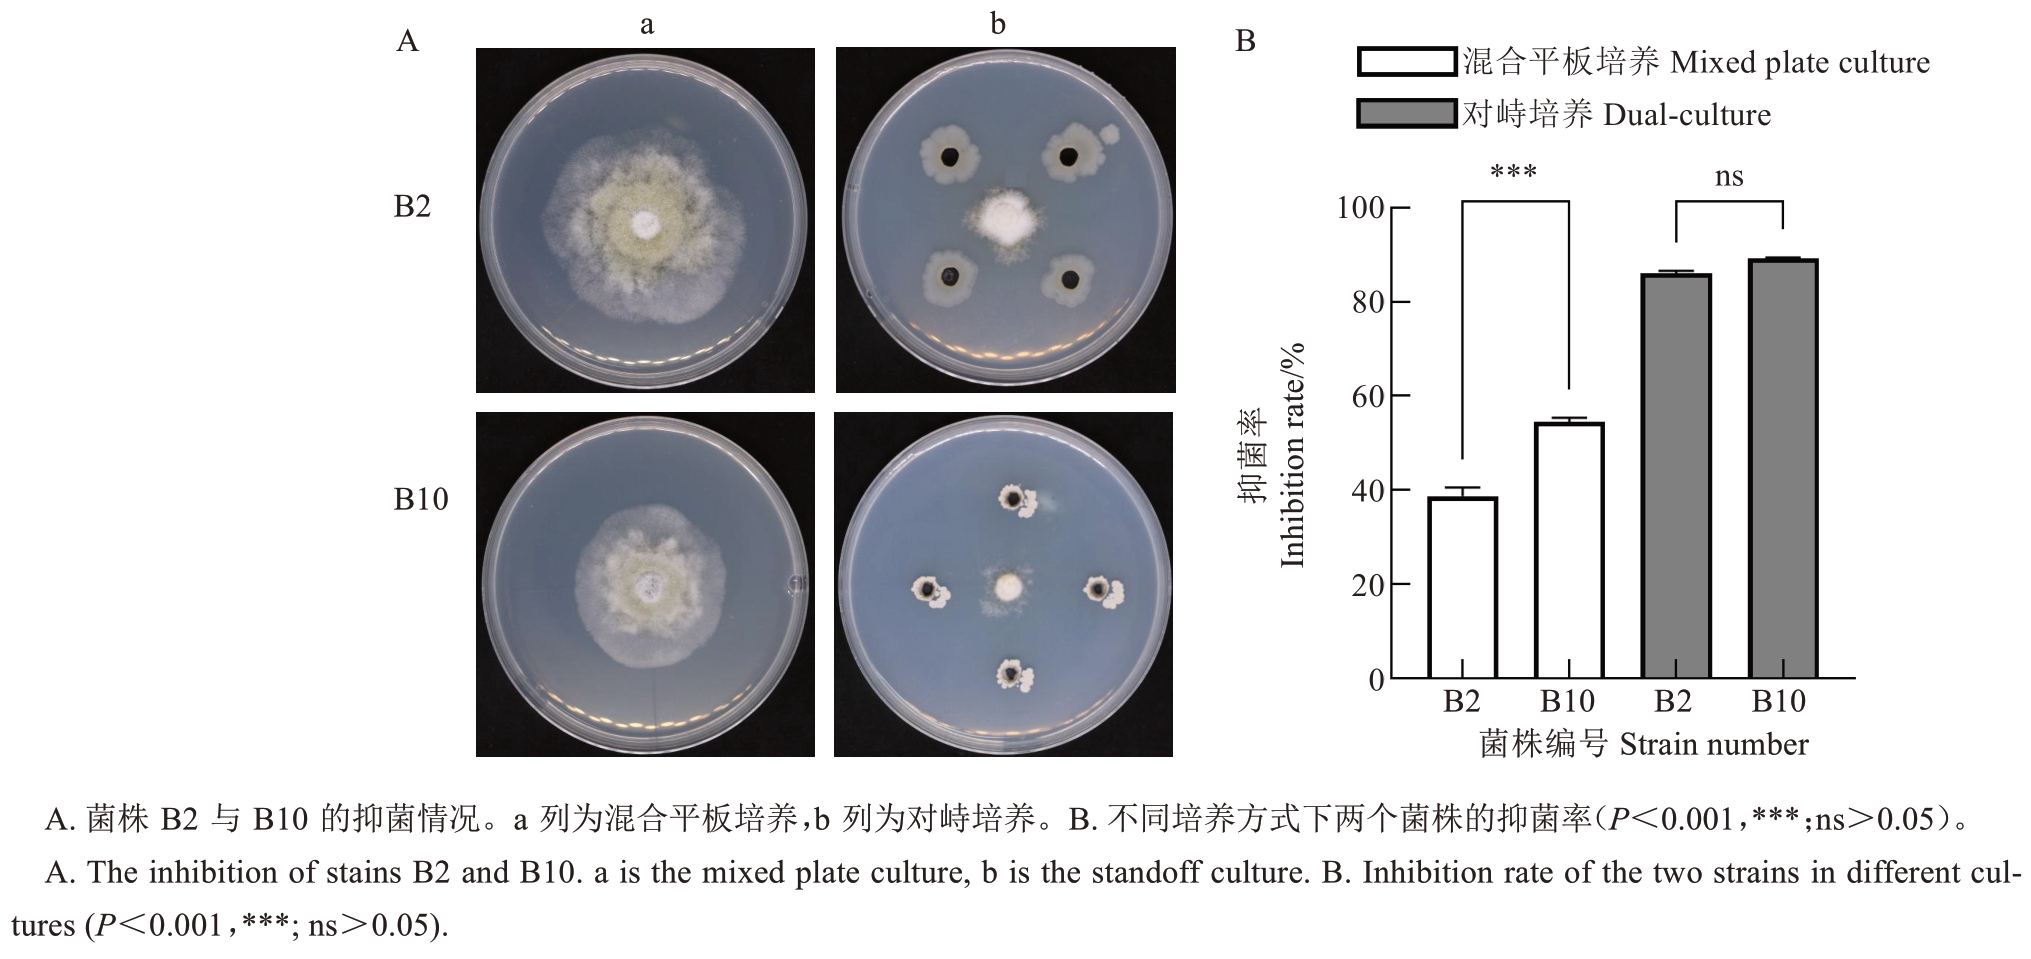

梨具有极高的经济价值,在全球范围内广泛种植,是中国第三大果树。目前,梨品种已有3000 余个,且仍在不断增加[1]。梨产业是中国农业发展的重要组成部分,在优化农业生产结构和增加农民收入方面发挥着重要作用。然而,尽管培育和推广的优质品种越来越多,但是中国梨的单位面积产量仍处于较低水平。根据FAO 2021年的数据,北美地区梨的年平均产量为36.63 t·hm-2,而中国仅为19.24 t·hm-2。这一现状与中国多地梨树病害的暴发密切相关[2-3]。近年来,梨树病害在全国各地频繁发生,尤其是一些新病害,由于对其缺乏了解,无法及时有效地进行防控,极大地降低了梨的产量和品质。
树木腐烂病即树木烂皮病,枝枯型症状是典型发病症状之一,主要发生在杨树、月季、梨、苹果等造林树种、观赏树种以及经济树种上[4-5]。病原物多来自壳囊孢属(Cytospora spp.)及其有性型黑腐皮壳属(Valsa spp.)和间座壳属(Diaporthe spp.)等[6-8]。已报道的梨树枯枝病病原菌多为黑腐皮壳属(Valsa sp.)成员。致病菌侵染树体的小枝或弱枝后迅速扩展,引起枝干大面积枯死,导致树势衰弱,梨产量和果实品质下降[8-10]。
随着化学农药的使用,环境污染和抗药性问题日益严重,生物防治因环保、无残留和可持续等优势,正逐步成为重要的替代方案[11]。植物内生菌是指在不引起宿主异常的情况下,长期生活于植物组织内部能够与宿主建立稳定互惠关系的微生物群体[11-14]。内生菌不仅参与植物生长调节和抗逆反应,还可以通过与病原菌竞争营养物质(如碳水化合物、氮和氧)及生态位,优先占据感染位点,从而抑制病原菌在寄主植物内的生长,是重要的生物防治资源[12]。袁洪波等[13]从梨树腐烂病发病枝条中分离获得的产紫青霉(Penicillium purpurogenum)菌株JK2对病原菌V. pyri 的生长具有良好的抑制作用;徐琳赟等[14]通过组织分离法从香梨中分离出的克雷伯氏菌属(Klebsiella sp.)细菌TN50与梨火疫病病菌(Erwinia amylovora)存在较强的竞争作用。
2024 年5 月,在哈尔滨市发现一株枝枯病发病严重的梨树。通过传统形态学与分子生物学方法对该病害的病原物种类进行鉴定;同时利用组织分离法分离梨树枝干的内生细菌,并从中筛选高效生防菌株,旨在为梨树的合理管护、开发梨树病害绿色防控技术提供菌种资源和理论依据。
1 材料和方法
1.1 病害标本采集与病原物分离、接种
从野外采集病害标本后,带回实验室采用单孢分离法分离病原菌。具体步骤为:将带有分生孢子器的枝条分别浸泡在2%次氯酸钠和75%酒精中各1 min,然后用无菌水冲洗,并用吸水纸吸干表面水分。使用灭菌的手术刀切开分生孢子器,用无菌针挑取内部物质,置于装有无菌水的离心管中充分振荡。经稀释后将悬浮液滴加到画有网格线的PDA 平板上,并标记单孢处。随后,将平板放置于25 ℃培养箱中避光培养,待其萌发后立即转板,在体视显微镜下挑取尖端菌丝进行多次纯化,直至获得纯菌落。将健康的梨树枝条采集至实验室进行水培。在对枝条进行消毒处理后,采用3 种接种方式:烧伤(使用酒精灯外焰灼烧2~3 s,直至听到表皮破裂的声音)、刺伤(使用昆虫针刺透枝干表皮,刺孔数量为7~8个)和无伤。以培养7 d的病原菌PDA平板的菌落边缘菌饼为接种体进行致病性测验,接种完成后,使用沾有无菌水的脱脂棉将接种部位包裹,并用封口膜缠绕以保持湿度,48 h 后去除。以空白PDA 平板作为对照,每种处理重复20组[4,7]。所有接种材料均直接放置于室内阴凉处,室内温度控制在(24±3) ℃,空气相对湿度为45%±10%。同时,每隔48 h用自来水冲洗枝条下端并更换水体。
1.2 病原物鉴定
1.2.1 形态学鉴定 将病害标本枝干上的分生孢子器体制成纵切片,在显微镜下进行形态学观察,测量分生孢子器、分生孢子梗和孢子大小。测量时随机选择测量对象,孢子数目不少于50 个,孢子大小用长度(a/b/c/d)、宽度(e/f/g/h)以(a-)b~c(-d) μm×(e-)f~g(-h) μm 的形式表示,80%的测量数值在b~c、f~g之间,a、e 代表测量最小值,d、h 代表测量最大值,其余结构测量数量不少于30 个。对获得的纯菌落的形态及产孢情况进行观察记录[15]。
1.2.2 分子生物学鉴定 以病原菌的纯培养菌丝为材料,使用博迈德植物基因组提取试剂盒抽提病原菌DNA基因组,并使用引物对ITS1(5′-CCGTAGGTGAACCTGCGG- 3′)/ITS4(5′- TCCTCCGCTTATTGATATGC-3′)、LR0R(5′-GTACCCGCTGAACTTAAGC-3′)/LR7(5′-TACTACCACCAAGATCT-3′)和EF1-728(5′-CATCGAGAAGTTCGAGAAGG-3′)/EF1-986(5′-TACTTGAAGGAACCCTTACC-3′)分别扩增病原菌的核糖体DNA 基因(ITS)、核糖体大亚基(LSU)和转录延伸因子(Tef-1α)三个基因片段,反应体系和程序根据试剂说明书设置[7]。扩增产物经凝胶电泳检测合格后送至生物公司测序。获得序列信息后,进行BLAST 相似性检索,根据blast 结果下载相关序列。使用MAFFT v7对每个区域独立排列序列,使用Gblocks自动剪切,在Phylosuite v1.2.3 中串联序列后,使用ModelFinder v2.2.0 筛选最佳拟合模型,分别利用IQ-TREE 和Mr Bayes 3.2.6 构建最大似然树和贝叶斯树,系统发育树通过FigTree 1.4.3进行可视化[16-17]。
1.3 内生细菌的分离筛选与抑菌谱测定
采用组织分离法分离内生细菌:将梨树枝干进行消毒处理(方法同1.1)后剥下表皮并裁成5 mm长的方块,将内部贴至培养基,置于25 ℃培养箱黑暗培养,待其长出菌落后,不断划线纯化细菌。
使用平板对峙法筛选生防细菌:将分离的细菌接种至LB 液体培养基中,30 ℃、120 r·min-1振荡培养24 h备用。初筛时,在PDA平板上接种直径5 mm的病原菌菌饼,于左右两侧2.5 cm处,使用盖玻片蘸取发酵液等距划线,线长1.5 cm。复筛时,(1)菌液经121 ℃灭菌20 min后,与PDA 培养基按体积比1∶1 混合制备平板接种病原菌菌饼;(2)将菌饼接种于普通PDA 平板上,在菌饼的上下左右2.5 cm 处打孔,滴加20 μL 发酵液上清液(12000 r·min-1 离心2 min)。以上试验均以空白LB 液体培养基作为对照,每组处理3 个生物学重复。待对照组菌落满板后,采用十字交叉法测量菌落直径,按照下面公式计算抑菌率。
以实验室保存的林木枝干病害病原菌为靶标菌,将筛选的生防细菌同复筛(2)的方法开展对峙试验测定其抑菌谱。
1.4 高效生防菌株的鉴定
1.4.1 形态学与生理生化鉴定 将拮抗菌株划线接种于LB 固体培养基中,30 ℃恒温培养箱培养3 d 后在体视显微镜下观察单菌落形态特征;使用AOBOX 染色剂(04-001)进行革兰氏染色,采用HBI 芽孢杆菌生化鉴定条(HBIG14)对其进行生理生化测定,具体操作参照相关说明书。
1.4.2 分子生物学鉴定 以生防细菌的摇培液为材料,使用天根细菌基因组提取试剂盒提取生防细菌DNA基因组,使用引物对27F(CCGTAGGTGAACCTGCGG)/1496R(TCCTCCGCTTATTGATATGC)和引物对gyrB-F(GAAGTCATCATGACCGTTCTGCAYGCN)/gyrB-R(AGCAGGGTACGATGTGCCGAGCCRTCN)分别扩增16S 核糖体RNA(16S rDNA)和促旋酶B(gyrB)序列,串联序列后使用MEGA 12.0以最大似然法构建系统发育树,其余同1.2.2[11-14]。
2 结果与分析
2.1 发病症状
病害主要发生在东北林业大学城市林业基地,寄主为观赏树种秋水梨(Pyrus ussuriensis)。发病植株多为老龄树,整体发病率接近50%。病部主要集中在树干下部的1~3年生新生枝条上。
健康的秋水梨枝条表皮光滑,色泽均匀(图1-A)。被病原菌侵染后,发病初期,表皮上可见若干水渍状、略呈隆起的小斑点,病斑周围常伴有淡褐色晕圈;发病后期,病组织明显肿胀,颜色加深,树皮出现纵向或裂口式开裂,病部变为暗褐色至黑色,表面密布黑色分生孢子器,多数呈圆形或类圆形,明显突起。病斑常常在多个部位同时发生,严重时相邻病斑相连成片,导致树皮组织干枯、木质部裸露,部分枝条因病组织脆化而自然折断或枯死(图1-B~C)。

图1 自然发病症状与致病性测定结果
Fig. 1 Symptoms of natural infection and results of pathogenicity assay
2.2 病原物分离与致病性验证
通过挑取单孢子萌发的菌落不断培养和纯化,最终获得3 株纯菌落。经菌丝形态、产孢情况比对与DNA 测序,确为同一物种,后转入斜面培养基保存,编号为LA-1。
试验期间,枝条表现出良好的生命力,接种部位始终保持正常的枝条色泽、弹性和绿色的叶片等特征。在统一条件下培养约18 d 后,刺伤处理的枝条表皮出现突起,至35 d 时可见分生孢子器(图1-D~F),整体发病率为65%;烧伤处理组于第12 天在接种位置出现圆形突起,随后周围形成晕圈,继续培养近30 d,隆起逐渐裂开,露出分生孢子器(图1-G~I),整体发病率达到75%;无伤接种组未见发病,接种部位未发生明显变化,与图1-A 相同。后续按照1.1 方法重新分离出的两株菌株的形态特征均与LA-1一致,ITS序列相似度为100%。因此,确定菌株LA-1是梨树烂皮病的病原菌。
2.3 病原物鉴定
2.3.1 形态学鉴定 病原菌分生孢子器埋生或半埋生于树枝表皮下,盘状,深褐色至黑色,直径650~950 μm,平均直径740 μm(n=30),分生孢子器多腔室,椭圆形至卵圆形,有共用壁,直径40~120 μm,平均直径75 μm(n=30)(图2-A~B);分生孢子梗无色透明,棍棒状,有时中部或顶端膨大,直径0.75~2.25 μm,平均直径1.5 μm(n=30)(图2-C);分生孢子单胞,椭圆形至圆柱状,两端不尖,含有大量油滴,有时凹陷,孢子幼时透明,老后变深棕色,大小为(15.5-)17.0~20.5(-22.5) μm×(6.0-)6.5~8.0(-8.5) μm,平均大小为18.5 μm×7.0 μm(n=50)(图2-D)。在PDA培养基上菌落初期呈白色,绒毛状,后期会产生橄榄色色素,黑暗培养至第13天即可形成分生孢子器(图2-E~F)。

图2 病原菌的形态学特征
Fig. 2 Morphological characteristics of the pathogen
2.3.2 分子系统学鉴定 通过测序分别获得ITS(603 bp)、LSU(1341 bp)和Tef-1α(170 bp)序列。经BLAST 分析,表明其ITS 和Tef-1α 序列与数据库中Aplosporella ginkgonis 和A. longipes 的多个菌株序列相似度均超过99.00%,最高达99.84%;而与拼接的LSU 序列相似度最高的是A. hesperidica(FXG04),其他相似序列均来自非Aplosporella属物种。但是以LSU 的单向片段检索,结果与上述2 个基因相似,可能原因是NCBI 数据库中该属真菌已上传的极大部分LSU 序列较短,仅约800 bp,检索时未能识别。经Blast 检索后选择相关序列构建系统发育树,拼接裁剪后用于分析的序列总长1435 bp,其中ITS 区域604 bp,LSU 区域830 bp,Tef-1α 区域125 bp,以Bagnisiella examinans 为外群。在最大似然系统发育中使用K80+R2+FO 模型进行5000 次超快bootstrap,在贝叶斯系统发育中使用K80+I 模型,运行至分裂偏差频率值为0.007 1。基于最大似然法得出的拓扑结构与贝叶斯法一致。在系统发育树中,LA-1 与菌株CFCC 70041 聚为一支,且处于Clade-A. ginkgonis中间位置(图3)。因此,根据形态学特征与系统学结果将LA-1鉴定为A. ginkgonis。

图3 基于ITS-LSU-Tef-1α 构建的联合系统发育树
Fig. 3 A three-gene phylogenetic tree based on ITS-LSU-Tef-1α
2.4 生防细菌筛选
通过分离与不断纯化,最终获得11 株细菌。经平板对峙试验发现在B1、B2 和B10 细菌处理下能够产生明显的抑菌圈,病原菌的生长受到抑制,B2和B10 菌株表现出最高的抑菌率(分别为86.87%和89.25%)(图4~图5)。后续复筛时发现在灭菌发酵液混合平板培养方式下,B10 对病原菌生长的抑制能力更为突出;而对峙培养下虽然二者的抑菌率无显著差异,但B2 处理下的病原菌菌落形态优于B10,菌丝更致密(图6)。值得注意的是,B10 的发酵液经121 ℃高温处理后抑菌率仍保持在50%以上,表明其所产抑菌物质具有良好的热稳定性。抑菌谱结果显示菌株B10 对其他植物病原菌(如壳囊孢属真菌)也具有良好的抑制能力(表1,图7)。
表1 菌株B10 对10 种病原菌生长的抑制率
Table 1 Inhibition of growth of 10 pathogenic bacteria by strain B10

序号Number a b c d e f g h i j病原菌Pathogenic bacterium Aplosporella ginkgonis Aplosporella javeedii Cytospora elaeagni Nectria ulmicola Phaeobotryon rhois Diaporthe cotoneastri Cytospora ceratosperma Phomopsis sp. HRP1 Cytospora sp. TAC1 Cytospora sp. RDC2病害(寄主)Disease (Host)风箱果枯枝病 Physocarpus amurensis branch blight disease桑树枯枝病Morus alba branch blight disease红瑞木烂皮病Cornus alba bark rot disease月季枯枝病Rosa chinensis branch blight disease榆树枯枝病Ulmus pumila branch wilt disease水曲柳枝枯病Fraxinus mandschurica blight disease蒙古栎烂皮病Quercus mongolica branch canker disease沙棘Hippophae rhamnoides紫椴Tilia amurensis兴安杜鹃 Rhododendron dauricum抑菌率Inhibition rate/%74.63±0.86 88.06±2.03 77.19±0.67 70.13±0.52 74.09±1.53 74.50±0.83 75.55±1.03 61.88±1.04 68.77±1.11 91.25±0.42

图4 初筛中11 株细菌对病原菌LA-1 的抑菌率
Fig. 4 Inhibition of pathogenic bacteria LA-1 by 11 strains of bacteria in the primary screen
图5 初筛中11 株细菌对病原菌LA-1 的抑菌情况
Fig. 5 Inhibition of pathogenic bacteria LA-1 by 11 strains of bacteria in the primary screen
图6 菌株B2 与B10 在不同方式下对病原菌LA-1 的抑制能力比较
Fig. 6 Comparison of the inhibitory ability of strains B2 and B10 against the pathogen LA-1 under different conditions

图7 菌株B10 对10 种病原菌生长的抑制情况
Fig. 7 Inhibition of the growth of 10 pathogenic bacteria by strain B10
2.5 生防细菌鉴定
在LB 固体培养基上,菌株B10 的菌落呈乳白色,不透明,形状近圆形,表面皱褶,边缘不整齐;革兰氏染色呈紫色,为阳性菌(图8),其他生理生化测定结果见表2。综合其形态学特征与生理生化结果,鉴定B10属于芽孢杆菌属细菌。
表2 菌株B10 的生理生化检测结果
Table 2 Physiological and biochemical assay results of strain B10

检测指标Test indicators厌氧生长 Anaerobic growth V-P试验 V-P test柠檬酸盐 Citrate丙酸盐 Propionate D-木糖 D-xylose L-阿拉伯糖 L-arabinose检测结果Test results 检测结果Test results-+--++检测指标Test indicators D-甘露醇 D-mannitol明胶液化 Liquefaction of gelatine 7%氯化钠生长 7% NaCl growth pH 5.7生长 pH 5.7 growth硝酸盐还原 Nitrate reduction淀粉水解 Starch hydrolysis++++++

图8 菌株B10 的形态
Fig. 8 Morphology of strain B10
通过测序分别获得16S rDNA(1418 bp)和gyrB(1109 bp)的序列。BLAST 分析结果表明16S rDNA序列与多条贝莱斯芽孢杆菌Bacillus velezensis、解淀粉芽孢杆菌B. amyloliquefaciens 的序列相似度为100%,其中B. velezensis 居多,且包括多个B. velezensis的全基因组序列;B10的gyrB基因检索结果较为明晰,与数据库中B. velezensis 的多个序列相似度为100%。基于BLAST 结果筛选相关序列后,采用最大似然法构建系统发育树,以Burkholderia pyrrocinia为外群,拼接裁剪后用于分析的序列全长2497 bp,其中16S rDNA 区域1403 bp,gyrB 区域1094 bp。菌株B10 与两株B. velezensis 聚为一支,得到显著支持(图9)。因此,综合其形态学鉴定、生理生化测定以及分子系统发育验证,鉴定生防菌B10 为贝莱斯芽孢杆菌B. velezensis。

图9 基于16S rDNA-gyrB 构建的最大似然系统发育树
Fig. 9 A Maximum likelihood phylogenetic tree constructed based on 16S rDNA-gyrB
3 讨 论
大单孢属Aplosporella真菌分布广泛,是一种重要的潜在植物病原真菌,常常寄生于植物枝条上,导致枝条枯死或形成溃疡,也可浸染叶片,对农业和林业生产具有显著的不利影响[18]。在发病率调查过程中发现,发病植株普遍存在长期未修剪的现象。植株下部新生枝条因长期处于荫蔽环境,光合作用受阻,进而导致生长势衰退、抗病性降低,为病原菌的侵染与定殖扩展创造了有利条件。致病性测定结果进一步证实,在3种处理方式下无伤接种的供试病原菌未能诱发病害症状,表明其致病力较弱,不具备直接侵入健康寄主组织的能力。明确病原菌是防治病害的前提。本研究鉴定的病原菌LA-1 的形态特征与A. ginkgonis的原始描述存在差异,例如,孢子是否含有油滴、分生孢子器腔室的大小等。此外,孢子具有明显凹陷,这一特征在Aplosporella物种中也从未被记载[15,19-21]。鉴于上述形态学差异与Blast 结果的不明确性,在系统学研究中,笔者选择了更为严谨的建树方法,但无论是进行单基因分析、任意两个基因的联合分析,还是三个基因的联合分析,结果均显示LA-1与A. ginkgonis的亲缘关系极为密切。因此,最终将LA-1 鉴定为A. ginkgonis。正如Jeewon 等[22]所述,在鉴定真菌物种时,应谨慎对待物种间易受环境影响的连续表型差异,例如孢子颜色、形状和大小等特征。因此,除非系统发育分析能够提供有力的支持,否则不应仅凭这些微观差异来界定物种。有研究曾将风箱果枯枝病的病原菌鉴定为A. longipes,即与LA-1亲缘关系较近的菌株AFX1-AFX3,但经笔者仔细核对该文献发现其病菌实际应是A. ginkgonis[23]。这可能是由于NCBI 数据库中菌株CFCC 89660/89661的学名尚未更新(数据检索日期截至2025年6月19 日)。在A. ginkgonis 被描述为新种时,原始文献指出由于寄主植物的关联,误将该物种鉴定为寄主为桑树的A. longipes,并上传了分子序列。此外,A. ginkgonis 与A. longipes 在形态上极为相似,因此导致了这一误解[11]。据笔者了解,本研究是Aplosporella属真菌侵染梨树的国内首次报道。结合以往研究及NCBI数据库的记载,A. ginkgonis已被报道可侵染银杏、桑树、枸杞、颤杨、火炬树、风箱果以及梨树等多种景观树种和经济树种,充分体现了其丰富的寄主多样性与较强的危害潜力。这一现象再次表明,仅凭新寄主的发现而描述大单孢属新种的做法并不科学,Aplosporella 属急需开展系统的分类修订工作[24-25]。值得注意的是,本研究中梨树的发病区域距离此前记录的风箱果枯枝病发生地仅约1 km,这提示两种病害之间可能存在近距离的自然传播或人为传播。作为分生孢子型真菌,A. ginkgonis 可以通过风雨传播,也能借助修剪工具在人工操作中扩散。如果病枝未能及时清除,或在修剪过程中缺乏有效的消毒措施,均可能加速其在不同树木间的传播与蔓延。因此,在城市绿化带或林业系统中,该病原菌具有一定的扩散风险,特别是在老龄植株或冠层稠密、通风不良的区域更易发生和流行。基于该病害的发病规律和病原物传播特点,应以“修剪+卫生清理+药剂防治+生物防控”为主要防治策略。春季及时对老龄植株进行修剪,疏除过密枝条,改善通风透光条件;应及时剪除病枝并集中销毁,修剪工具使用前后应消毒,避免人为传播;提前对植株喷施保护性杀菌剂,发病后及时使用治疗性药剂进行干预;施用相关生防菌剂,增强植株抗性,抑制病原菌的扩展。
基于A. ginkgonis 的广寄主性,开发高效生防菌株尤为迫切。植物内生菌是重要的生物防治资源,其中芽孢杆菌类细菌广泛存在于植物体内,能够有效抑制大多数病原菌[12,26]。芽孢杆菌还具有易于生产和便于保存使用的优点,因此在生物制剂中占有较大比例[27-28]。Bacillus velezensis 对多种植物病原细菌和真菌都具有较强的抑制活性,并且具有促进植物生长的特性。袁洪波等[28]应用B. velezensis 菌株P2-1 防治草莓褐色叶斑病菌时发现其不仅抗性显著,还具有良好的促生作用,能够有效定殖在草莓叶片表面;李永丽等[29]的研究指出从野苹果果实中分离的B. velezensis菌株Mr12对苹果轮纹病菌Botryosphaeria dothidea 具有良好的预防效果,并且具备产生多种肽聚糖、聚酮糖类抗性化合物及细胞壁水解酶的能力。以往的研究从梨树的枝干或果实中分离出多种芽孢杆菌,这些菌株对相关病原菌具有良好的生物防治作用。例如,鲁晏宏等[30]从香梨枝干表皮分离的16 株芽孢杆菌属细菌对香梨黑斑病病原菌Alternaria alternata 均表现出一定的抑制作用,其中效果最佳的菌株为B. velezensis NY2和NY7;郭志华等[31]从砀山梨中分离的枯草芽孢杆菌(B. subtilis)DSL-9对砀山梨炭疽病的病原菌Colletotrichum gloeosporioides展现出较高的抑菌活性,该菌株还对果实内的多酚氧化酶(PPO)、过氧化氢酶(POD)、超氧化物歧化酶(SOD)和过氧化物酶(CAT)活性均存在正向调节作用。以上研究充分表明了芽孢杆菌在梨树病害防控中的广阔应用前景。同时,鉴于该菌株抑菌作用显著,热稳定性较高,生防潜力巨大,后续将系统研究其田间定殖能力、环境适应性与发酵工艺,以期开发可应用于实际林木病害防治的生防产品。
4 结 论
本研究将哈尔滨市的梨树枝枯病病原菌鉴定为Aplosporella ginkgonis,从梨树枝干中分离的贝莱斯芽孢杆菌B10 对病原菌Aplosporella ginkgonis LA-1 具有良好的拮抗作用且抑菌谱广,具有较高的应用价值。
[1] 张绍铃,谢智华. 我国梨产业发展现状、趋势、存在问题与对策建议[J]. 果树学报,2019,36(8):1067-1072.ZHANG Shaoling,XIE Zhihua. Current status,trends,main problems and the suggestions on development of pear industry in China[J]. Journal of Fruit Science,2019,36(8):1067-1072.
[2] 赵德英,徐锴,袁继存,程存刚,闫帅. 世界梨主产国产销概况及发展趋势分析[J]. 中国果树,2016(2):94-100.ZHAO Deying,XU Kai,YUAN Jicun,CHENG Cungang,YAN Shuai. The world's main pear producing countries production and marketing overview and development trend analysis[J]. China Fruits,2016(2):94-100.
[3] 张诗涵. 木霉的分离鉴定及钩状木霉对梨病害生防潜能的评价[D]. 武汉:华中农业大学,2023.ZHANG Shihan. Isolation and identification of Trichoderma spp. and evaluation of biocontrol potential of Trichoderma hamatum on pear diseases[D]. Wuhan:Huazhong Agricultural University,2023.
[4] 武崇高,朱桐,崔云龙,刘雪峰,刘晴,刁桂萍. 月季枯枝病病原物鉴定、生物学特性与防治药剂筛选[J/OL]. 浙江农林大学学报,2025:1-15. (2025-07-14). https://kns.cnki.net/kcms/detail/33.1370.s.20250711.1951.002.html.WU Chonggao,ZHU Tong,CUI Yunlong,LIU Xuefeng,LIU Qing,DIAO Guiping. Identification,characterization and fungicide screening of the causal pathogen of branch blight in Rosa chinensis[J/OL]. Journal of Zhejiang A&F University,2025:1-15. (2025- 07- 14). https://kns.cnki.net/kcms/detail/33.1370.s.20250711.1951.002.html.
[5] ZHU L L,TANG L,TIAN X R,BAI Y Y,HUANG L L. Two polyketide synthase genes,VpPKS10 and VpPKS33,regulated by VpLaeA are essential to the virulence of Valsa pyri[J]. Phytopathology,2024,114(9):2071-2083.
[6] SHA S S,WANG Z,YAN C C,HAO H T,WANG L,FENG H Z.Identification of fungal species associated with apple canker in Tarim Basin,China[J]. Plant Disease,2023,107(5):1284-1298.
[7] 武崇高,朱桐,贾宁,刘雪峰,刁桂萍,王宇曦,逯昕明,王斌. 红瑞木烂皮病病原鉴定及生物学特性[J]. 东北林业大学学报,2024,52(10):124-130.WU Chonggao,ZHU Tong,JIA Ning,LIU Xuefeng,DIAO Guiping,WANG Yuxi,LU Xinming,WANG Bin. Pathogen identification and biological characteristics of Cornus alba bark rot disease[J]. Journal of Northeast Forestry University,2024,52(10):124-130.
[8] 丁丹丹,刘博,李爽,赵继荣,程国亭,回虹燕,徐成楠. 辽宁梨树枝枯病病原菌Diplodia seriata 的分离与鉴定[J]. 植物保护,2023,49(3):226-230.DING Dandan,LIU Bo,LI Shuang,ZHAO Jirong,CHENG Guoting,HUI Hongyan,XU Chengnan. Isolation and identification of the pathogen Diplodia seriata causing stem blight disease on pear in Liaoning[J]. Plant Protection,2023,49(3):226-230.
[9] 蒋晶晶,周昭旭,杜蕙,张美娇,李虹,申培增,陈爱昌. 甘肃地区梨树腐烂病的病原种类鉴定[J]. 中国果树,2023(10):84-88.JIANG Jingjing,ZHOU Zhaoxu,DU Hui,ZHANG Meijiao,LI Hong,SHEN Peizeng,CHEN Aichang. Identification of the pathogen of pear Valsa canker in Gansu area[J]. China Fruits,2023(10):84-88.
[10] 陈晓忍. 不同寄主来源腐烂病菌的生物学特性研究及防治梨腐烂病的药剂筛选[D]. 武汉:华中农业大学,2015.CHEN Xiaoren. Biological characteristics of the pathogens from different host plants caused canker and screening fungicide against pear Valsa canker[D]. Wuhan:Huazhong Agricultural University,2015.
[11] 刘志金,单路路,玛丽艳姑丽·吐尔迪,李彤,康启航,张锐,董宁,陈小飞. 核桃腐烂病拮抗菌Pseudomonas chlororaphis 的筛选、鉴定及其防病促生效果[J]. 果树学报,2025,42(1):170-184.LIU Zhijin,SHAN Lulu,Maliyanguli·Tuerdi,LI Tong,KANG Qihang,ZHANG Rui,DONG Ning,CHEN Xiaofei. Screening and identification of antagonistic bacterium Pseudomonas chlororaphis for walnut rot disease and its effect on promoting germination of seeds and growth of seedlings in walnut[J]. Journal of Fruit Science,2025,42(1):170-184.
[12] 张静怡,赵龙飞,刘梦洁. 植物内生菌多样性、功能及应用研究进展[J]. 微生物学报,2025,65(4):1446-1468.ZHANG Jingyi,ZHAO Longfei,LIU Mengjie. Progress in research concerning the diversity,function,and application of plant endophytes[J]. Acta Microbiologica Sinica,2025,65(4):1446-1468.
[13] 袁洪波,侯珲,周增强,王丽,涂洪涛. 梨树腐烂病拮抗真菌JK2 的分离和鉴定[J]. 果树学报,2021,38(10):1760-1766.YUAN Hongbo,HOU Hui,ZHOU Zengqiang,WANG Li,TU Hongtao. Isolation and identification of endophytic fungus JK2 antagonistic against pear Valsa canker caused by Valsa pyri[J].Journal of Fruit Science,2021,38(10):1760-1766.
[14] 徐琳赟,古丽孜热·曼合木提,韩剑,蒋萍,黄伟,罗明. 香梨内生拮抗细菌的筛选及对梨火疫病的生防潜力[J]. 西北植物学报,2021,41(1):132-141.XU Linyun,Gulizzier · Manhemuti,HAN Jian,JIANG Ping,HUANG Wei,LUO Ming. Screening of endophytic antagonistic bacteria from ‘Kuerlexiangli’ pear and their biocontrol potential against fire blight disease[J]. Acta Botanica Boreali-Occidentalia Sinica,2021,41(1):132-141.
[15] DU Z. Aplosporella ginkgonis (Aplosporellaceae,Botryosphaeriales),a new species isolated from Ginkgo biloba in China[J].Mycosphere,2017,8(2):1246-1252.
[16] NGUYEN L T,SCHMIDT H A,VON HAESELER A,MINH B Q. IQ-TREE:A fast and effective stochastic algorithm for estimating maximum-likelihood phylogenies[J]. Molecular Biology and Evolution,2015,32(1):268-274.
[17] RONQUIST F,TESLENKO M,VAN DER MARK P,AYRES D L,DARLING A,HÖHNA S,LARGET B,LIU L,SUCHARD M A,HUELSENBECK J P. MrBayes 3.2:Efficient Bayesian phylogenetic inference and model choice across a large model space[J]. Systematic Biology,2012,61(3):539-542.
[18] 金宇溪,王爽. 中国大单孢属真菌一新纪录种[J]. 生物技术通报,2012,28(5):185-186.JIN Yuxi,WANG Shuang. A new record species of the genus Aplosporella from China[J]. Biotechnology Bulletin,2012,28(5):185-186.
[19] EKANAYAKA A H,DISSANAYAKE A J,JAYASIRI S C,TOANUN C,JONES E B G,ZHAO Q,HYDE K D. Aplosporella thailandica;a novel species revealing the sexual-asexual connection in Aplosporellaceae (Botryosphaeriales)[J]. Mycosphere,2016,7(4):440-447.
[20] LIN L,BAI Y K,PAN M,TIAN C M,FAN X L. Morphology and molecular analyses reveal three new species of Botryosphaeriales isolated from diseased plant branches in China[J].MycoKeys,2023,97:1-19.
[21] DOU Z P,LU M,WU J R,HE W,ZHANG Y. A new species and interesting records of Aplosporella from China[J]. Sydowia,2017,69:1-7.
[22] JEEWON R. Establishing species boundaries and new taxa among fungi:Recommendations to resolve taxonomic ambiguities[J]. Mycosphere,2016,7(11):1669-1677.
[23] YAO C H,LIU X F,DIAO G P. First report of branch blight disease caused by Aplosporella longipes on Physocarpus amurensis in China[J]. Forest Pathology,2023,53(1):e12788.
[24] VERMA S K,YADAV S,SINGH R. Molecular phylogeny of Aplosporella abexaminans:A novel species revealing the second report of sexual-asexual connection in Aplosporellaceae (Botryosphaeriales) from India[J]. Phytotaxa,2021,525(3):205-222.
[25] ZHU H Y,TIAN C M,FAN X L. Studies of botryosphaerialean fungi associated with canker and dieback of tree hosts in Dongling Mountain of China[J]. Phytotaxa,2018,348(2):63.
[26] 张敏,张丽莉,王虹云,曹守军,姚建刚,张瑞清,刘安达,郑世伟,尹海波,李涛. 植物内生菌及其在番茄生长发育中的作用研究进展[J/OL]. 中国瓜菜,2025:1-15(2025-07-01). https://doi.org/10.16861/j.cnki.zggc.2025.0272.ZHANG Min,ZHANG Lili,WANG Hongyun,CAO Shoujun,YAO Jiangang,ZHANG Ruiqing,LIU Anda,ZHENG Shiwei,YIN Haibo,LI Tao. Research progress on endophytic bacteria in plants and their roles in the growth and development of tomato[J/OL]. China Cucurbits and Vegetables,2025:1-15(2025-07-01). https://doi.org/10.16861/j.cnki.zggc.2025.0272.
[27] XIAO S,CHEN N,CHAI Z X,ZHOU M D,XIAO C,ZHAO S Q,YANG X L. Secondary metabolites from marine-derived Bacillus:A comprehensive review of origins,structures,and bioactivities[J]. Marine Drugs,2022,20(9):567.
[28] 袁洪波,王卓妮,袁梦佳,覃艮红,史冰柯,周厚成,侯珲,王丽,涂洪涛. 贝莱斯芽胞杆菌菌株P2-1 对草莓褐色叶斑病菌的抑制活性及其促生作用[J]. 果树学报,2023,40(1):126-132.YUAN Hongbo,WANG Zhuoni,YUAN Mengjia,QIN Genhong,SHI Bingke,ZHOU Houcheng,HOU Hui,WANG Li,TU Hongtao. Antagonistic activity of Bacillus velezensis strain P2-1 against Tan-brown leaf spot of strawberry and its growth-promoting effect[J]. Journal of Fruit Science,2023,40(1):126-132.
[29] 李永丽,周洲,尹新明. 贝莱斯芽孢杆菌Mr12 预防苹果轮纹病等病害的潜力及其全基因组分析[J]. 果树学报,2021,38(9):1459-1467.LI Yongli,ZHOU Zhou,YIN Xinming. Potential and genomewide analysis of Bacillus velezensis Mr12 in preventing apple ring rot and other diseases[J]. Journal of Fruit Science,2021,38(9):1459-1467.
[30] 鲁晏宏,郝金辉,詹发强,王宁,侯新强,杨蓉,包慧芳,龙宣杞.香梨黑斑病病原菌分离及拮抗菌筛选鉴定[J]. 新疆农业科学,2022,59(10):2538-2545.LU Yanhong,HAO Jinhui,ZHAN Faqiang,WANG Ning,HOU Xinqiang,YANG Rong,BAO Huifang,LONG Xuanqi. Isolation of pathogenic bacteria and screening and identification of antagonistic bacteria of black spot of fragrant pear[J]. Xinjiang Agricultural Sciences,2022,59(10):2538-2545.
[31] 郭志华,段腾飞,江翠翠,王芳. 拮抗砀山梨炭疽菌的内生菌筛选及抑菌效果分析[J]. 食品科学,2018,39(12):185-190.GUO Zhihua,DUAN Tengfei,JIANG Cuicui,WANG Fang. Isolation of endophytic bacteria from Dangshan pear and their antagonistic effect against Colletotrichum gloeosporioides[J].Food Science,2018,39(12):185-190.